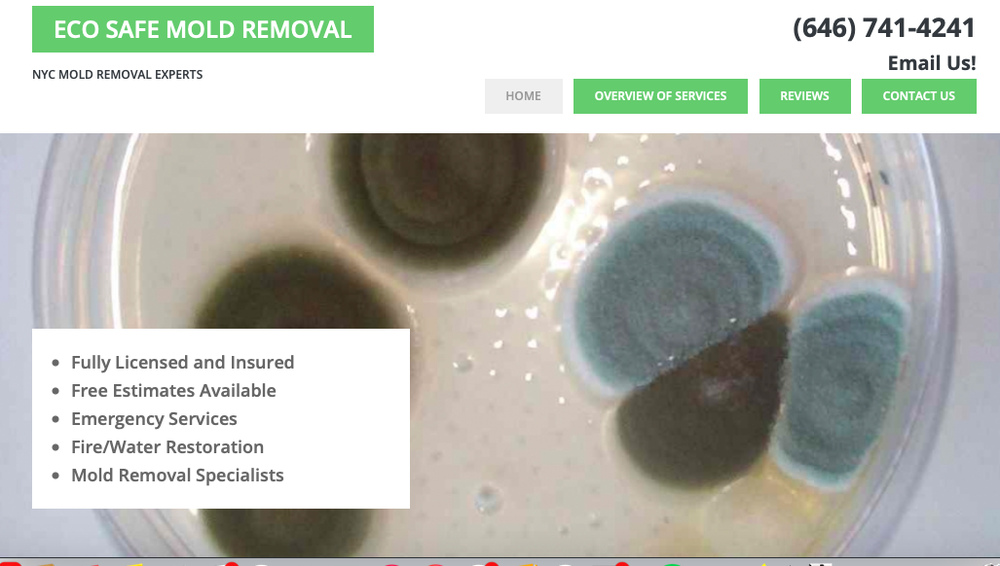
Eco Safe Mold Removal - mold inspector in New York, NY

Eco Safe Mold Removal
Mold Inspector in New York, New York
About Eco Safe Mold Removal
New York residents looking for environmental testing have Eco Safe Mold Removal at 80 Varick St, Ste 9B. They do not have Yelp reviews posted yet. Services include damage restoration and environmental testing. New York City and the Hudson Valley have a different market than upstate.
How They Can Help
Services at Eco Safe Mold Removal include damage restoration and environmental testing. Environmental testing and mold inspection tell you what is actually in your air and walls, which matters more than guessing. Call (646) 741-4241 to schedule.
What to Expect
Start by calling (646) 741-4241 to describe what you are seeing or smelling. They can tell you whether a visual inspection is enough or whether lab testing makes sense for your situation.
Service Area
Eco Safe Mold Removal is at 80 Varick St, Ste 9B in New York, NY. They serve the local area and surrounding communities.
Frequently Asked Questions
How long does a mold inspection take?
Does homeowners insurance cover mold?
When should I get a mold inspection?
How much does a mold inspection cost?
Where is Eco Safe Mold Removal?
Need a Cleaner Mold Case File?
MoldLedger helps homeowners and pros keep intake, photos, findings, and next steps in one clean case record.
Start a Case